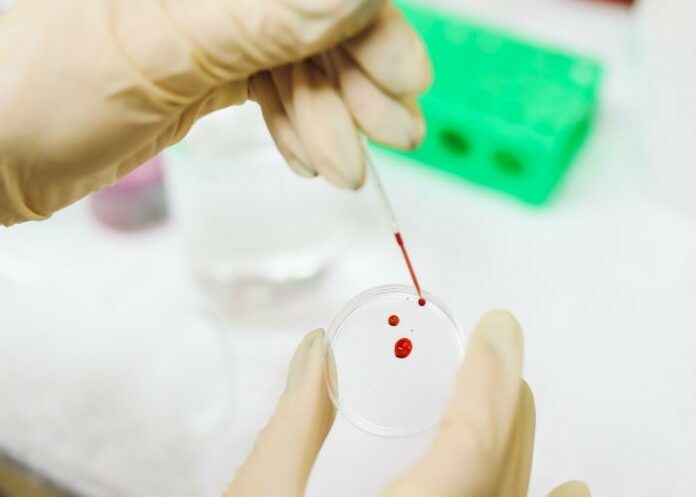

Doctors have told health services to prepare for a new era of cancer screening after a study found a simple blood test could spot multiple cancer types in patients before they develop clear symptoms – possibly paving the way for saving lives by earlier detection, surgery and treatment.
The Pathfinder study offered the blood test to more than 6 600 adults aged 50 and over, and detected dozens of new cases of disease. Many cancers were at an early stage and nearly three-quarters were forms not routinely screened for, reports The Guardian.
It is the first time results from the Galleri test, which looks for cancer DNA in the blood, have been returned to patients and their doctors, to guide cancer investigations and any necessary treatment.
The Galleri test has been described as a potential “gamechanger” by NHS England, which is due to report results from a major trial involving 165 000 people next year. Doctors hope the test will save lives by detecting cancer early enough for surgery and treatment to be more effective, but the technology is still in development.
“What’s exciting about this new paradigm and concept is that many of these were cancers for which we do not have any standard screening,” Dr Deb Schrag, a senior researcher on the study at the Memorial Sloan Kettering Cancer Centre in New York, told the European Society for Medical Oncology meeting (ESMO) in Paris at the weekend.
In the Pathfinder study, 6 621 adults aged 50 and over were offered the Galleri blood test. For 6 529 volunteers, the test was negative, but it flagged a potential cancer in 92 of them.
Further tests confirmed solid tumours or blood cancer in 35 people, or 1.4% of the study group. The test spotted two cancers in a woman who had breast and endometrial tumours.
Beyond spotting the presence of disease, the test predicts where the cancer is, allowing doctors to fast-track the follow-up work needed to find and confirm a cancer. “The signal of origin was very helpful in directing the type of work-up,” said Schrag. “When the blood test was positive, it typically took under three months to get the work-ups completed.”
The test identified 19 solid tumours in tissues such as the breast, liver, lung and colon, but it also spotted ovarian and pancreatic cancers, which are typically detected at a late stage and have poor survival rates.
The remaining cases were blood cancers. Out of the 36 cancers detected in total, 14 were early stage and 26 were forms of the disease not routinely screened for.
Further analyses found the blood test was negative for 99.1% of those who were cancer-free, meaning only a small proportion of healthy people wrongly received a positive result. About 38% of those who had a positive test turned out to have cancer.
Schrag said the test was not yet ready for population-wide screening and that people must continue with standard cancer screening while the technology is improved. “But this still suggests a glimpse of what the future may hold with a really very different approach to cancer screening,” she said.
Fabrice André, the director of research at Gustave Roussy Cancer Centre in Villejuif, France, said: “Within the next five years, we will need more doctors, surgeons and nurses, and more diagnostic and treatment infrastructure, to care for the rising number of people who will be identified by multi-cancer early detection tests.”
Naser Turabi, the director of evidence and implementation at Cancer Research UK, said: “Blood tests for multiple types of cancer used to belong in the realm of science fiction, but now they are an area of cancer research that is showing promise for patients.
“Research like this is crucial for making progress against late-stage cancers and giving more patients the chance of a good outcome. The Pathfinder trial results give us a better understanding of how frequently cancer is found by this blood test in people who haven’t been previously diagnosed.
“But we will need data from larger studies to fully assess this test and other similar tests in development, especially to understand whether people actually survive for longer after their cancer is picked up.”
Study details
A prospective study of a multi-cancer early detection blood test
D Schrag, CH McDonnell, L Nadauld, CA Dilaveri, EA Klein, R Reid, CR Marinac, K. Chung, M Lopatin, ET Fung, TM Beer.
Presented at the ESMO Congress on 11 September 2022
Abstract
Background
A validated blood-based multi-cancer early detection (MCED) test uses cfDNA and machine learning to detect a common cancer signal across >50 cancer types and predict cancer signal origin (CSO). PATHFINDER is a prospective study in a screening population that evaluated the clinical feasibility of MCED testing.
Methods
Participants were aged ≥50 y with or without additional cancer risk factors. Blood samples were collected, cfDNA analysed, and MCED test results returned (MCED-E, early version). Cancer status was confirmed at 1 year for all participants. The primary outcome was the extent of diagnostic testing required for resolution after cancer signal detected by MCED-E. Those with cancer signal and confirmed cancer are true positive (TP), without confirmed cancer are false positive (FP). Diagnostic evaluation was at the discretion of the treating physician. Key secondary outcomes included test performance and safety. A pre-specified analysis evaluated a refined test version (MCED-Scr) using the participants’ banked specimens without return of results.
Results
The MCED-E test detected cancer signal in 1.4% (92/6621) of participants with analysable samples. Cancer was confirmed in 38% (35/92). Specificity was 99.1% (6235/6290). A total of 73% (24/33) of TPs had diagnostic resolution in <3 months. MCED-Scr performance was similar with MCED-E. Four AEs were reported (0.06%); none were due to confirmatory diagnostic procedures.
Conclusions
MCED testing was feasible in outpatient practice without significant AEs and with a PPV of approximately 40%. Studies to refine multi-cancer screening techniques are ongoing.
See more from MedicalBrief archives:
NHS pilots simple blood test that screens for 50 types of cancer
Blood test may detect 10 types of cancer before tumour develops
Blood test may detect 5 cancers up to 4 years earlier in asymptomatic patients